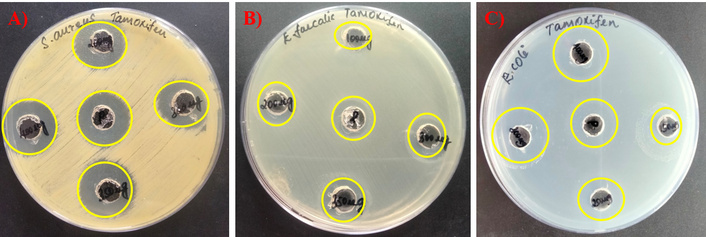
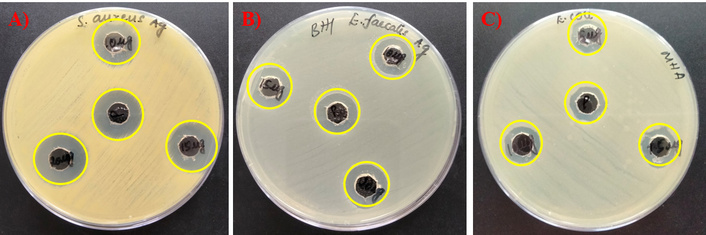
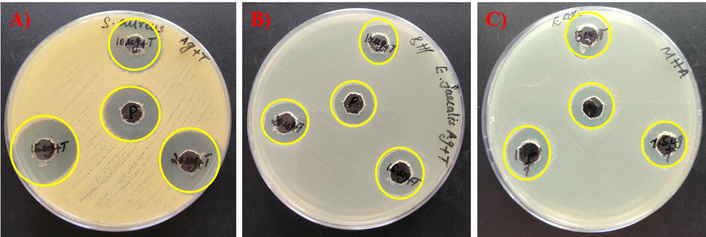

Affiliation:
1Department of Basic Medical Sciences, College of Medicine, Prince Sattam bin Abdulaziz University, Al-Kharj 11942, Saudi Arabia
Email: tb.ahmed@psau.edu.sa
ORCID: https://orcid.org/0009-0000-1576-1724
Affiliation:
1Department of Basic Medical Sciences, College of Medicine, Prince Sattam bin Abdulaziz University, Al-Kharj 11942, Saudi Arabia
ORCID: https://orcid.org/0000-0003-4826-3603
Affiliation:
1Department of Basic Medical Sciences, College of Medicine, Prince Sattam bin Abdulaziz University, Al-Kharj 11942, Saudi Arabia
ORCID: https://orcid.org/0000-0002-0806-4442
Affiliation:
1Department of Basic Medical Sciences, College of Medicine, Prince Sattam bin Abdulaziz University, Al-Kharj 11942, Saudi Arabia
ORCID: https://orcid.org/0000-0003-4163-6374
Affiliation:
1Department of Basic Medical Sciences, College of Medicine, Prince Sattam bin Abdulaziz University, Al-Kharj 11942, Saudi Arabia
ORCID: https://orcid.org/0000-0002-2416-4304
Affiliation:
2Department of Biomedical Sciences, College of Medicine, King Faisal University, Al-Ahsa 31982, Saudi Arabia
ORCID: https://orcid.org/0000-0001-6871-5027
Affiliation:
1Department of Basic Medical Sciences, College of Medicine, Prince Sattam bin Abdulaziz University, Al-Kharj 11942, Saudi Arabia
ORCID: https://orcid.org/0000-0003-3994-4845
Affiliation:
2Department of Biomedical Sciences, College of Medicine, King Faisal University, Al-Ahsa 31982, Saudi Arabia
ORCID: https://orcid.org/0000-0002-3700-6479
Explor Med. 2025;6:1001369 DOI: https://doi.org/10.37349/emed.2025.1001369
Received: June 20, 2025 Accepted: October 28, 2025 Published: November 10, 2025
Academic Editor: Anna Maria Spagnolo, University of Genova, Italy
Aim: Healthcare-associated infections (HAIs), especially when multidrug-resistant bacteria cause them, pose serious challenges resulting in higher healthcare expenses, increased morbidity, and higher mortality, and thus, there is a need for new antimicrobial agents. Repurposing an old drug for new applications is an important trend, and in the present study, an anti-breast cancer drug, Tamoxifen, has been screened alone and in combination with silver nanoparticles (AgNPs) synthesized using Abutilon indicum Linn. against Enterococcus faecalis, Escherichia coli, and Staphylococcus aureus, which are involved in HAIs.
Methods: The drug and the combination were subjected to antimicrobial potential analysis and the determination of minimum inhibitory concentrations (MICs) by agar diffusion and microdilution methods. Biofilm formation assays were performed using the crystal violet method to understand biofilm prevention and eradication efficiencies. The synergism in the activities of the drug and the combination with selected antibiotics was studied using checkerboard assay, and the cytotoxic effects of the drug and the combination on L929 cells were analyzed using MTT assay.
Results: Tamoxifen and the AgNPs showed promising antibacterial activities, and the MICs of the drug were found to be 62.5 µg/mL (E. coli), 31 µg/mL (S. aureus), and 125 µg/mL (E. faecalis). When combined with AgNPs, Tamoxifen showed a 4-fold reduction in the MIC. The drug also displayed promising antibiofilm activities as it reduced mature S. aureus biofilms by 91%, E. faecalis biofilms by 88%, and E. coli biofilms by 73%. AgNPs alone reduced 91%, 91%, and 81% of biofilms by S. aureus, E. faecalis, and E. coli, respectively, and the combination treatment revealed 92% of S. aureus, 94% of E. faecalis, and 82% of E. coli biofilm eradication at their MICs. Tamoxifen also showed synergism when combined with antibiotics—ampicillin and rifampicin and the AgNPs in combination with Tamoxifen revealed no cytotoxic effect on L929 cells at their MICs.
Conclusions: All the mentioned studies suggest that Tamoxifen alone and in combination with AgNPs has promising antibacterial and anti-biofilm activities, and it can be developed for better treatment options against HAIs as they are safe for eukaryotic cells.

Healthcare-associated infections (HAIs), previously known as nosocomial infections, are the infections acquired either within 48 hours of hospital admission or within one month after receiving healthcare. These infections pose significant challenges to the patients, healthcare providers, and healthcare workers alike, with estimates suggesting that between 4% and 12% of hospitalized patients may develop one or more HAIs, some even after getting discharged from the hospital [1–3]. HAIs encompass a variety of conditions, including surgical site infections (SSIs), central line-associated bloodstream infections (CLABSIs), catheter-associated urinary tract infections (CAUTIs), ventilator-associated pneumonia (VAP), Clostridium difficile infections, and infections caused by multidrug-resistant (MDR) organisms such as Klebsiella pneumoniae [4–6]. These infections often lead to increased patient suffering, elevated healthcare costs, higher morbidity, and greater mortality [7].
In recent years, bacterial infections have posed a significant threat to public health, with over a million cases attributed to the alarming rise in antimicrobial resistance against multiple classes of commonly used antibiotics [8, 9]. The management and treatment of HAIs caused by these drug-resistant bacteria present a major challenge [1, 5]. A key factor contributing to the persistence and severity of many bacterial infections is the formation of biofilms—a process where pathogenic microorganisms colonize tissues and medical devices, leading to chronic infections [10, 11]. Recent studies estimate that approximately 80% of bacterial infections in humans involve biofilms, which are associated with increased morbidity and mortality rates [12–14].
Biofilms are communities of microorganisms embedded within a self-produced polymeric matrix that acts as a physical barrier, limiting communication between bacterial cells and reducing the penetration of antibacterial agents [15, 16]. This protective layer hinders the effectiveness of antibiotics by decreasing their diffusion into the biofilm, often leading to treatment failure in biofilm-associated infections [17]. Furthermore, bacteria within biofilms can develop resistance not only to antimicrobial agents but also to host immune defense, making these infections particularly difficult to eradicate [12, 18, 19]. Consequently, managing HAIs which involve indwelling medical devices remains a significant clinical challenge.
Among the microorganisms known to form biofilms on implanted medical devices, Enterococcus faecalis, Staphylococcus aureus, and Escherichia coli are the primary contributors to healthcare-associated bacterial infections [20–22]. These biofilm-forming pathogens present significant treatment challenges due to their ability to develop resistance to antibiotics. Consequently, the growing threat of antimicrobial resistance has emphasized the need for innovative therapeutic approaches. Several studies have highlighted the potential of drug repurposing—using the existing drugs for new therapeutic applications—as a promising strategy to effectively target biofilm-associated bacterial infections. This approach benefits from the well-established pharmacological and toxicity profiles of these drugs, reducing the risks associated with developing entirely new agents [23–25]. Furthermore, combining repurposed drugs with nanoparticles, particularly metal-based nanoparticles like silver nanoparticles (AgNPs), has shown considerable potential in enhancing antimicrobial efficacy [26, 27]. Recent research continues to demonstrate that nanoparticle-based strategies are effective in combating bacterial infections and inhibiting biofilm formation. Specifically, AgNPs, both alone and in combination with antibiotics, have been shown to significantly reduce biofilm biomass, especially against MDR pathogens [28–30].
Over the past decades, numerous studies have demonstrated the antibacterial properties of various non-steroidal anti-inflammatory drugs against clinically important Gram-negative and Gram-positive bacteria [31–34]. Tamoxifen, primarily known for its use in breast cancer treatment [35], is an affordable and widely accessible medication with a well-established safety profile. It has also been repurposed in experimental infection models for its activity against several pathogenic bacteria, including Pseudomonas aeruginosa, Acinetobacter baumannii, and E. coli, and has exhibited antifungal properties as well [36, 37]. In this study, we aimed to evaluate the antibacterial activity of Tamoxifen alone and in combination with AgNPs synthesized using Abutilon indicum Linn. The antibacterial effects were tested against S. aureus, E. coli, and E. faecalis, which are common biofilm-forming pathogens linked to HAIs. Beyond assessing activity against free-floating (planktonic) bacteria, we also examined the ability of Tamoxifen and its combination with AgNPs to inhibit biofilm formation and disrupt established biofilms. Additionally, the potential synergistic effects of Tamoxifen combined with commonly used antibiotics were evaluated to explore enhanced antimicrobial efficacy.
All the microbiological media, chemicals/reagents, antibiotics, drugs, etc. including Brain Heart Infusion agar (BHA), Mueller Hinton Agar (MHA), rifampicin (HiMedia, Cas No:13292-46-1), ampicillin (HiMedia, MB104-5G), Tamoxifen (Sigma-Aldrich Chemicals, Cas No: 10540-29-1), silver nitrate, etc. were purchased from companies including Sigma Aldrich Chemicals Private Limited, India and HiMedia Laboratories Private Limited, India. The bacterial cultures of E. faecalis, S. aureus, and E. coli (ATCC numbers 29212, 25923, and 25922 respectively) were procured from American Type Culture Collection Centre, USA. For the assays, MHA was used to grow E. coli, and the BHA was used for culturing E. faecalis and S. aureus. The overnight-cultures used for the study were growth-adjusted to 1 × 106 CFU/mL. To prepare Tamoxifen stock solution, 25 mg of drug was dissolved in 1 mL of 100% ethanol. From the stock solution, the working solution of drug Tamoxifen (1 mg/mL in water) was prepared and used throughout the study. The controls were 5 µg rifampicin and 5 µg ampicillin antibiotics. All the experiments were done in triplicate.
To a volume of 500 mL of double-distilled water, 5 g of A. indicum powder (whole plant) was added and boiled for 30 min. The prepared plant crude extract was filtered through Whatmann No.1 filter paper and used as reducing agent for the synthesis of AgNPs. For synthesis, 10 mL of A. indicum extract was added to 1 mM silver nitrate solution (90 mL) and then, this reaction mixture was kept in a domestic microwave oven for 4 min with a power of 300 W [38].
Using the well-diffusion method [39], the antibacterial potentials of Tamoxifen, AgNPs alone, and in combination with Tamoxifen were investigated against the selected pathogens. Shortly, the overnight cultures (0.5 McFarland unit) of E. coli, E. faecalis, and S. aureus were swabbed on the prepared sterile MHA plate and BHA plate surfaces, followed by the well drilling. Each well was loaded with various amounts of Tamoxifen, AgNPs alone, and in combination with Tamoxifen, and then incubated. By measuring the growth inhibition zone diameter (in mm) around the wells, the antibacterial potentials of the Tamoxifen, AgNPs alone, and in combination with Tamoxifen against the selected pathogens were determined. Ampicillin and rifampicin served as positive control antibiotics.
Using the microdilution method [40], the drug Tamoxifen, AgNPs alone and in combination with Tamoxifen were analyzed for their MICs against E. coli, E. faecalis, and S. aureus. Briefly, in a plate well, 250 µg/mL of Tamoxifen was subjected to serial dilution up to 1.9 µg/mL, 10 µg/mL of AgNP was diluted up to 0.07 µg/mL in the respective broth. Then, the overnight cultures (1 × 106 CFU/mL) of E. faecalis, S. aureus, and E. coli were added to the wells and incubated. Then, using a spectrophotometer, the ODs were read at 600 nm.
The potentials of Tamoxifen, AgNPs alone and in combination with Tamoxifen on pre-formed biofilms by the selected bacteria viz., E. coli, E. faecalis, and S. aureus were studied with polystyrene plates [39]. The drug Tamoxifen was subjected to serial dilution to 1.9 µg/mL, AgNP was diluted up to 0.07 µg/mL and silver combination with Tamoxifen (1× MIC, 0.5× MIC, 0.25× MIC, 0.125× MIC, 0.06× MIC) were added in respective broths and the selected bacterial cultures (1 × 106 CFU/mL) were added to allow the biofilm formation, for 96 hours and then they were incubated. After incubation, with phosphate-buffered saline, the wells were washed, and then using methanol, the cells were fixed. Then, the wells were subjected to crystal violet staining. Then, the wells were washed with PBS solution and destained with ethyl alcohol-acetone complex. Then, at a wavelength of 570 nm, the obtained purple color was spectrophotometrically measured. The untreated wells were considered as negative controls.
To determine the anti-biofilm effect of Tamoxifen, AgNPs alone and in combination with Tamoxifen on mature biofilms of selected pathogens, the biofilm formation assay was performed using the crystal violet method [40]. For the experiment, overnight cultures (1 × 106 CFU/mL) of test organisms were added in 96-well plate and allowed for biofilm formation till 96 hours. Then, the mature biofilms were treated with MICs of Tamoxifen, AgNPs alone, and in combination with Tamoxifen for 24 hours. Later, the untreated and treated biofilms were subjected to PBS treatment followed by methanol fixation, and staining with 0.1% crystal violet for 30 min. Destaining was performed with ethanol and acetone complex. Finally, the obtained product with purple color was spectrophotometrically measured at 570 nm. The untreated wells were considered as the negative controls.
To study the synergistic effect of Tamoxifen with commercial antibiotics, ampicillin (against E. faecalis and S. aureus) and rifampicin (against E. coli), the checkerboard assay was performed [41]. In brief, Tamoxifen and the antibiotics were added at an amount above the MIC level (2× MIC), MIC, and three amounts were below the MIC (0.5× MIC, 0.25× MIC, and 0.125× MIC) level in combinations into well, followed by the addition of overnight cultures of the selected bacteria and incubated. Later, the plates were read spectrophotometrically at 600 nm, and the FICI (fractional inhibitory concentration index) was calculated by FIC of Tamoxifen, rifampicin, and ampicillin. Here, the FIC of Tamoxifen was obtained by dividing the MIC of Tamoxifen in combinations with the Tamoxifen original MIC.
AgNPs in combination with the drug Tamoxifen were studied for their cytotoxicity on L929 (mouse fibroblast cell line from NCCS (National Centre for Cell Science, Pune) by MTT assay [42]. The received cells, which were free from mycoplasma contamination, were grown in DMEM (Dulbecco’s Modified Eagle’s Medium) supplemented with 10% fetal bovine serum and the cells (2 × 104) were cultured and incubated with different amount (1.25 µg/mL + 15.5 µg/mL, 2.5 µg/mL + 31 µg/mL, 3.75 µg/mL + 46.5 µg/mL, 5 µg/mL + 62 µg/mL, 6.25 µg/mL + 77.5 µg/mL, 7.5 µg/mL + 93 µg/mL) of AgNPs and Tamoxifen combinations in 5% CO2 at 37°C for 24 hours. Then, for the formation of formazan, 20 µL of MTT solution was added. It was then subjected for incubation at 37°C for 3 to 4 hours. Then, to dissolve the formazan crystals, DMSO (200 µL) was added, and ODs were read at 570 nm and 690 nm. The positive control was 0.1% triton X100 and the negative controls were untreated cells. The experiment was done in triplicate and the entire experiments were repeated independently to ensure the reproducibility. The percentage of cell viability was found by: percentage of cell viability = [(OD of treated cells)/(OD of untreated cells)] × 100.
For all the experiments, such as MIC determination, effect on biofilm formation and eradication, checker board assay and MTT, the standard error was calculated from means ± standard deviations. The statistical significance was calculated for biofilm formation, biofilm eradication, checker board assay and MTT assay using student unpaired student t-test (online tool). The statistical significance was considered when P < 0.05.
The green-based AgNPs were synthesized using the medicinal plant A. indicum as reducing agents and the schematic representation of green-based AgNPs is shown in Figure S1A. On microwave oven exposure, the reaction mixture containing silver nitrate and the reducing agent showed a color change (colorless to dark reddish brown) within 4 min, which indicated the formation of AgNPs. Further, the formation of AgNPs was examined and confirmed by recording the UV-Vis absorption spectrum (300 nm to 700 nm range) as shown in the graph, Figure S1B. λmax (maximum absorption) was seen at 430 nm, which confirmed the formation of AgNPs. Based on UV spectra of the AgNP, the calculated particle size was approximately 40 nm–60 nm [43–45].
The antibacterial potentials of the drug Tamoxifen, AgNPs, and their combinations (AgNP-T complex) against E. faecalis, S. aureus, and E. coli were evaluated, and the corresponding zones of growth inhibition are presented in Figures 1, 2, 3. A gradual increase in the size of the inhibition zones was observed with all tested agents against the bacterial pathogens. Notably, the AgNP-T complex exhibited enhanced antibacterial activity compared to Tamoxifen or AgNPs alone. These results indicate that the combination significantly increased the diameter of the inhibition zones, demonstrating a synergistic effect.
Antimicrobial activity of the drug Tamoxifen against. (A) S. aureus, (B) E. faecalis, and (C) E. coli.
Antibacterial activity of AgNPs against the test pathogens. (A) S. aureus, (B) E. faecalis, and (C) E. coli. AgNPs: silver nanoparticles.
Antibacterial activity of AgNPs in combination with Tamoxifen against tested microbes. (A) S. aureus, (B) E. faecalis, and (C) E. coli. AgNPs: silver nanoparticles.
The MICs of the drug Tamoxifen, AgNPs, and their combinations (AgNP-T complex) were found against E. faecalis, S. aureus, and E. coli, and the MICs are shown in Table 1 and the graphs plotted as shown in Figure S2, Figure S3, and Figure S4A–C. For the bacterium S. aureus, 31 µg/mL of Tamoxifen was required to suppress its growth, and against E. faecalis it was 125 µg/mL, and against E. coli the MIC was determined as 62.5 µg/mL of Tamoxifen. Similarly, in the case of AgNPs, the calculated MICs were 5 µg/mL against S. aureus and E. faecalis whereas the amount of AgNPs required to inhibit the growth of E. coli was 2.5 µg/mL. At the same time, the MICs of AgNPs in combination with Tamoxifen have been reduced when compared to their original MICs individually. Here, the least amount needed for E. coli growth inhibition was found as 0.625 µg/mL of AgNP and 15.5 µg/mL of Tamoxifen. In the same way, for S. aureus, 1.25 µg/mL of AgNPs and 7.75 µg/mL of Tamoxifen. Similarly, 1.25 µg/mL of AgNP and 31 µg/mL of Tamoxifen were needed to stop the E. faecalis growth which indicates the quantity of antibacterial agents was reduced when combined with another drug.
MIC of Tamoxifen, AgNPs, and their combinations (AgNP-T complex) against E. faecalis, S. aureus, and E. coli.
| Agents | Organisms | ||
|---|---|---|---|
| S. aureus | E. faecalis | E. coli | |
| Tamoxifen | 31 µg/mL | 125 µg/mL | 62.5 µg/mL |
| AgNPs | 5 µg/mL | 5 µg/mL | 2.5 µg/mL |
| AgNP-T | 1.25 µg/mL of AgNP and 7.75 µg/mL of T | 1.25 µg/mL of AgNP and 31 µg/mL of T | 0.625 µg/mL of AgNP and 15.5 µg/mL of T |
MIC: minimal inhibitory concentration; AgNPs: silver nanoparticles; AgNP-T: AgNP-Tamoxifen complex; T: Tamoxifen.
The effect of Tamoxifen, AgNPs, and their combinations (AgNP-T complex) on the formation of biofilm by E. faecalis, S. aureus, and E. coli was analyzed, and the findings are presented in Figures 4, 5, 6. The results clearly show that Tamoxifen, AgNPs, and their combination effectively inhibited biofilm formation by the tested pathogens on polystyrene surfaces at concentrations up to their respective MIC levels. Although a general trend of increased biofilm formation was observed in untreated controls, treatment with Tamoxifen, AgNPs, and especially the AgNP-T complex significantly reduced biofilm development by S. aureus, E. coli, and E. faecalis.

Effect of the drug Tamoxifen on biofilm-formation of S. aureus, E. faecalis, and E. coli. **: indicates the statistical significance was highly significant when compared to untreated (P < 0.0001).

Effect of AgNP against S. aureus, E. faecalis, and E. coli biofilm formation. **: indicates the statistical significance was highly significant when compared to untreated (P < 0.0001). AgNP: silver nanoparticle.

Effect of AgNPs in combination with Tamoxifen against S. aureus, E. faecalis, and E. coli biofilm formation. **: indicates the statistical significance was highly significant when compared to untreated (P < 0.0001). AgNPs: silver nanoparticles; MIC: minimal inhibitory concentration; Ag-T: AgNP-Tamoxifen complex.
The effects of the drug Tamoxifen, AgNPs, and their combinations (AgNP-T complex) on mature biofilm by E. faecalis, S. aureus, and E. coli were investigated, and the quantification was made using the crystal violet method, as shown in Figure 7. The tested amounts (MICs) of Tamoxifen, AgNPs, and their combinations (AgNP-T complex) have efficiently eliminated the mature biofilms by the selected bacterial pathogens on the polystyrene surfaces. In the case of the biofilms formed by the pathogen S. aureus, E. faecalis, and E. coli, the drug Tamoxifen MICs could eliminate 91%, 88%, and 73% of biofilms after 24 hours treatment, respectively. Similarly, when analyzed, it was found that there was a reduction of 91%, 91%, and 81% in biofilms formed by S. aureus, E. faecalis, and E. coli after AgNPs MIC treatment, respectively. A significant reduction by 92%, 94% and 82% was also noted in the case of biofilms formed by S. aureus, E. faecalis, and E. coli after treatment with MIC of AgNP-T complex.

Effect of Tamoxifen, AgNPs, and their combinations (AgNP-T complex) on mature biofilms of S. aureus, E. faecalis, and E. coli after treatment with MICs. TAMO: Tamoxifen; AgNP: silver nanoparticles; AGT: AgNP-Tamoxifen complex; **: indicates the statistical significance was highly significant when compared to untreated (P < 0.0001).
The synergism in the activities on the selected pathogens by the drug Tamoxifen with the antibiotics ampicillin and rifampicin was studied and the findings are shown in Figure S5A–C. When combined with the antibiotics, a reduction in the level of MIC from 31 µg/mL to 15.5 µg/mL against S. aureus was observed. Similarly, in the case of E. faecalis, also, the MIC declined from 125 µg/mL to 62.5 µg/mL when applied with a combination of Tamoxifen and ampicillin. When the Tamoxifen was combined with rifampicin, a reduced MIC level was observed in the case of E. coli (62.5 µg/mL to 31 µg/mL) also. The calculated FICI for Tamoxifen with ampicillin and rifampicin as 0.5 proved the synergistic effect, indicating Tamoxifen could be used in combination with any of these antibiotics.
The cytotoxicity of AgNPs in combination with the drug Tamoxifen was studied on L929 cells by MTT assay and the results have been shown as the percentage of the viability of the cells in Figure 8. After 24 hours of incubation, AgNPs in combination with Tamoxifen showed no toxicity at their MIC level, and at the same time, the percentage of live cells was reduced upon increasing the agents.

MTT assay. (A) Microscopic image of untreated L929 cells at 40× magnification, (B) cells treated with AgNPs in combination with Tamoxifen at 40× magnification, and (C) percentage of live cells after treatment. Scale bar: 20 µm; **: indicates the statistical significance was highly significant when compared to untreated (P < 0.0001). AgNP (Ag): silver nanoparticle; T: Tamoxifen.
The rise of MDR organisms and the diminishing effectiveness of current antibiotics have created an urgent need to explore alternative therapeutic options. One promising approach involves repurposing existing drugs with well-established safety profiles for antimicrobial use. In this study, Tamoxifen—an anti-breast cancer drug—was investigated for its antimicrobial potential against E. faecalis, E. coli, and S. aureus, all of which are commonly associated with healthcare-related infections. The drug was tested both alone and in combination with AgNPs. For the synthesis of AgNPs, an extract of A. indicum Linn. was employed as a natural reducing and stabilizing agent. The reduction of silver ions was facilitated by phytochemicals present in the extract, such as flavonoids, phenolics, tannins, and terpenoids known for their redox activity. Functional groups like hydroxyl (–OH) and carbonyl (C=O) in these compounds contribute electrons to reduce silver ions (Ag+) into metallic silver (Ag0). Additionally, these phytochemicals bind to the surface of the nanoparticles, acting as capping agents to prevent aggregation and ensure stability [46].
The study found that the drug Tamoxifen possesses antimicrobial activities against the selected HAI-causing pathogens, viz., E. faecalis, S. aureus, and E. coli, and it was enhanced when combined with AgNPs. The antibacterial activity was found to be dose dependent, as evidenced by the increasing zone of inhibition diameter with higher concentrations of the test sample, which suggests a direct correlation between the concentration and its antibacterial efficacy. Also, at higher concentrations, a greater number of nanoparticles or compounds are accessible for interaction with bacterial cells, leading to enhanced membrane disruption resulting cell death. This observation is consistent with previous study wherein agar well diffusion assay revealed a positive correlation between nanoparticle concentration and inhibition zone size [47]. Moreover, the dose-dependent antibacterial activity noted in the study supports the possibility of AgNPs as effective antibacterial agents when applied at suitable concentrations.
Also, the MICs of Tamoxifen were reduced from 31 µg/mL to 7.75 µg/mL against S. aureus, 125 µg/mL to 31 µg/mL against E. faecalis, and 62.5 µg/mL to 15.5 µg/mL against E. coli when combined with AgNP, demonstrating 4-fold enhancement in antibacterial activity. This finding aligns with previous report, where dibucaine and niflumic acid exhibited a 4-fold MIC reduction against S. aureus when used in combination: dibucaine with kanamycin and tetracycline, and niflumic acid with streptomycin and ampicillin. These findings suggest that dibucaine and niflumic acid have the potential to enhance the efficacy of conventional antibiotics, highlighting their clinical relevance as adjunct therapies [48]. Another study demonstrated that ciprofloxacin bound gold nanoflowers achieved a 7.5-fold reduction in MIC against S. aureus [49]. These findings support the concept that nanomaterials can enhance the efficacy of existing drugs through synergistic or additive effects. Our results provide further evidence for the potential of combinatorial drug repurposing strategies, particularly when coupled with biologically active nanomaterials, to overcome antimicrobial resistance and improve therapeutic outcomes.
The combination used in the present study demonstrated strong antibacterial and effective antibiofilm activity on silicone discs. Similarly, AgNPs conjugated with levofloxacin have been evaluated for their antimicrobial efficacy against methicillin-resistant S. aureus (MRSA), both alone and in combination, with MICs reported at 12 µM and 10 µM, respectively [50]. Another study explored resin composites embedded with ciprofloxacin-loaded AgNPs for their activity against key oral pathogens such as E. faecalis and Streptococcus mutans, revealing enhanced antibacterial effects against these dental pathogens [51]. In a more recent investigation, selective estrogen receptor modulators including Tamoxifen, raloxifene, and toremifene, showed significant antimicrobial activity against major Gram-negative bacteria such as A. baumannii, P. aeruginosa, and E. coli, with MIC values reported in 8 mg/L range [52]. Similarly, another study reported the antibacterial potential of Tamoxifen against vancomycin-resistant E. faecalis and MRSA, with MIC values of 8 mg/L against both drug-resistant strains [36].
Apart from antimicrobial potential, Tamoxifen was investigated for its ability to prevent biofilm formation and to eradicate mature biofilms on surfaces. The study revealed that Tamoxifen does not allow the tested microbes to form biofilms resulting in inhibition of biofilm formation up to their lowest level. The findings of the present study were supported by various studies wherein various repurposing drugs like etoposide-A, sertraline, and penfluridol were investigated for their ability to inhibit S. aureus and E. faecalis biofilm formation [53–55]. A study conducted by [42] in which the AgNPs were functionalized with amikacin (AK) and mercaptopoly carboxylic acid and were evaluated for their antibacterial and anti-biofilm activities alone and in combined with hyperthermia against P. aeruginosa, E. coli, K. pneumonia, and A. baumannii showed a result supporting the present findings.
To overcome antibiotic resistance, the application of a drug-drug combination is an excellent method for the treatment procedure because the chances of developing resistance to multiple antibiotics instantaneously are minimal resulting in the rapid elimination of resistant pathogens [56, 57]. Therefore, the present study evaluated the combined effect of the drug Tamoxifen with two antibiotics and the results showed synergism in activities. Hence, Tamoxifen can be used on any of these antibiotics for better treatment options against infections by E. faecalis, S. aureus, and E. coli. Tamoxifen shows synergistic activity with the antibiotic’s ampicillin and rifampicin (FICI = 0.5), indicating a synergistic interaction. The enhanced antibacterial activity observed in our study may be attributed to multiple synergistic mechanisms, including: membrane disruption, where Tamoxifen is reported to interact with bacterial membranes of test pathogens, resulting in increased membrane permeability and membrane integrity disruption, which enhance the intracellular accumulation of both ampicillin and rifampicin, leading to significant bactericidal effect enhancement [36, 52]. Efflux pump inhibition is an important key resistant mechanism for drug resistance and Tamoxifen and their metabolites are reported to inhibit efflux pump activity in bacterial as well as mammalian cells, which may enhance the intracellular absorption of ampicillin and rifampicin, thereby increasing antibacterial activity. Membrane potential disruption and ion homeostasis, wherein Tamoxifen inhibits bacterial membrane potential and ion gradients, resulting in proton motive force failure, which increases antibiotic diffusion into the cell, thereby synergy was noted [58]. Further, modulation of gene expression related to resistance and multi-targeted stress response, Tamoxifen can alter the bacterial gene expression involved in cell envelope synthesis, antibiotic resistance pathways and stress response which may sensitize the test pathogens to used antibiotics leads weakening the bacterial defence response. These combined mechanisms enhanced the antibacterial effects observed with the Tamoxifen–ampicillin–rifampicin combination.
This study was correlated with previous findings wherein Tamoxifen combined with known antibiotic polymyxin-B against A. baumannii, E. coli, and P. aeruginosa and showed synergistic activity against those microbes [59]. In contrast, the study investigated the synergistic activity of carvedilol, amlodipine, amitriptyline, and various antibiotics, including gentamicin, tetracycline, and selected carbapenems, against both susceptible and MDR A. baumannii. The combination of carvedilol with gentamicin showed a FICI of 0.2813, indicating a synergistic effect. Additionally, the combination of carvedilol with amlodipine yielded a FICI of 0.5625, suggesting an additive effect. Similarly, the combinations of amlodipine with tetracycline and amitriptyline with tetracycline both resulted in FICI values of 0.75, also indicating additive effects. Notably, combinations of carvedilol, amlodipine, and amitriptyline with tetracycline demonstrated synergistic activity by reducing the MIC by up to four-fold from 2 to 0.5 μg/mL [60].
HAIs are very common, and when they are caused by drug-resistant, biofilm-forming bacterial pathogens, the treatment and management of the condition become challenging. So, in a trial to suggest a new antibacterial, antibiofilm agent against prominent HAI-causing bacterial pathogens, the present study employed a drug repurposing approach, and the anti-breast cancer drug Tamoxifen alone and in combination with AgNPs were analyzed for their activities against E. faecalis, S. aureus, and E. coli. The MIC of the drug against the pathogens were quantified and the drug Tamoxifen was evaluated for its biofilm inhibition capabilities and mature-biofilm elimination properties which proved that it has promising potentials. The investigation for synergism with two known antibiotics revealed the combined, enhanced effects of Tamoxifen. The study suggests that Tamoxifen combination with AgNPs has promising antibacterial and antibiofilm activities on the selected bacterial pathogens. The findings of this study proposed important clinical and translational relevance by representing the potential of repurposing the FDA-approved anti-breast cancer drug Tamoxifen as an effective antimicrobial agent when combined with AgNPs. The Tamoxifen-AgNP conjugate showed strong antibacterial and antibiofilm activity against MDR pathogens commonly associated with HAIs, which are a major challenge in hospital settings. This strategy not only extends the therapeutic utility of Tamoxifen but also introduces a novel nanomedicine-based approach to combat resistant infections. The results lay the groundwork for further preclinical studies and eventual clinical translation, offering a promising adjunct or alternative to conventional antibiotics, particularly in the era of rising antimicrobial resistance.
AgNPs: silver nanoparticles
BHA: Brain Heart Infusion agar
FICI: fractional inhibitory concentration index
HAIs: healthcare-associated infections
MDR: multidrug-resistant
MHA: Mueller Hinton agar
MIC: minimal inhibitory concentration
MRSA: methicillin-resistant Staphylococcus aureus
The supplementary figures for this article are available at: https://www.explorationpub.com/uploads/Article/file/1001369_sup_1.pdf.
TBMA: Conceptualization, Resources, Data curation, Software, Formal analysis, Supervision, Funding acquisition, Validation, Investigation, Visualization, Methodology, Writing—original draft, Project administration, Writing—review & editing. MMP: Conceptualization, Resources, Data curation, Formal analysis, Validation, Investigation, Visualization, Methodology, Writing—original draft, Writing—review & editing. MHEB: Software, Investigation, Methodology, Writing—original draft, Writing—review & editing. AMRA: Software, Validation, Investigation, Methodology, Writing—original draft. MSK: Formal analysis, Investigation, Visualization, Writing—original draft, Writing—review & editing. NS: Validation, Investigation, Methodology, Writing—original draft. SG: Data curation, Methodology, Writing—original draft. AEM: Validation, Methodology, Writing—original draft, Writing—review & editing. All authors read and approved the submitted version.
The authors declare no conflicts of interest.
Not applicable.
Not applicable.
Not applicable.
All data are available from the corresponding author upon reasonable request.
The authors extend their appreciation to Prince Sattam bin Abdulaziz University for funding this research work through project number [PSAU/2023/03/26788]. The funders had no role in study design, data collection and analysis, decision to publish, or preparation of the manuscript.
© The Author(s) 2025.
Open Exploration maintains a neutral stance on jurisdictional claims in published institutional affiliations and maps. All opinions expressed in this article are the personal views of the author(s) and do not represent the stance of the editorial team or the publisher.
Copyright: © The Author(s) 2025. This is an Open Access article licensed under a Creative Commons Attribution 4.0 International License (https://creativecommons.org/licenses/by/4.0/), which permits unrestricted use, sharing, adaptation, distribution and reproduction in any medium or format, for any purpose, even commercially, as long as you give appropriate credit to the original author(s) and the source, provide a link to the Creative Commons license, and indicate if changes were made.
View: 548
Download: 17
Times Cited: 0